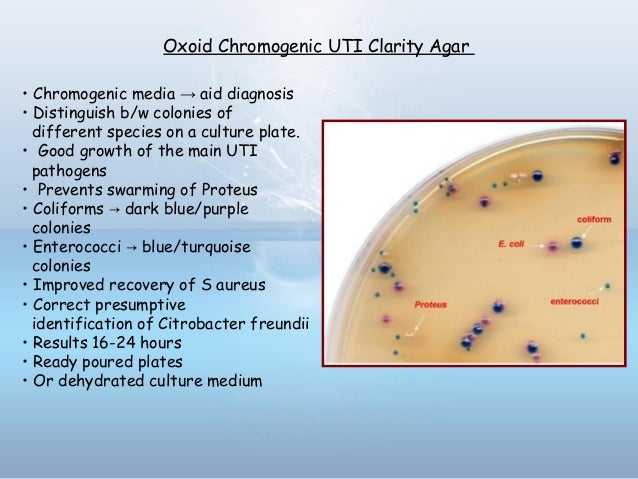
Urinary tract infections

If you are looking for PPT - The Gram-Negative Bacteria of Medical Importance PowerPoint you've came to the right page. We have 9 Images about PPT - The Gram-Negative Bacteria of Medical Importance PowerPoint like E.coli infections linked to chopped salad kits, CDC warns, UTI treatment reduces E. coli, may offer alternative to antibiotics and also PPT - The Gram-Negative Bacteria of Medical Importance PowerPoint. Here it is:
PPT - The Gram-Negative Bacteria Of Medical Importance PowerPoint
 www.slideserve.com
www.slideserve.com pseudomonas gram negative aeruginosa skin importance bacteria medical ppt powerpoint presentation rash eruption
Urinary Tract Infections
www.slideshare.net
www.slideshare.net uti chromogenic oxoid infections tract urinary
Urinary Tract And Bladder Infections | The Doctors TV Show
bladder urinary tract
E.coli Infections Linked To Chopped Salad Kits, CDC Warns
 www.news-medical.net
www.news-medical.net coli bacteria escherichia cdc linked infection intestinal infections gram negative rod ecoli warns chopped salad kits diarrhea uti urinary tract
Pseudomonas Aeruginosa Bacteria, SEM - Stock Image - F001/0227
 www.sciencephoto.com
www.sciencephoto.com aeruginosa pseudomonas sem micrograph electron scanning bacteria colored
Urinary Tract Infections
 www.slideshare.net
www.slideshare.net urinary tract uti saprophyticus staphylococcus pathogens pathogen
Staphylococcus
 www.slideshare.net
www.slideshare.net staphylococcus epidermidis location uti
UTI Treatment Reduces E. Coli, May Offer Alternative To Antibiotics
 medicine.wustl.edu
medicine.wustl.edu coli uti antibiotics infection ecoli
Significant Bacteriuria
 www.slideshare.net
www.slideshare.net bacteriuria asymptomatic idsa
Uti treatment reduces e. coli, may offer alternative to antibiotics. Bacteriuria asymptomatic idsa. Pseudomonas aeruginosa bacteria, sem